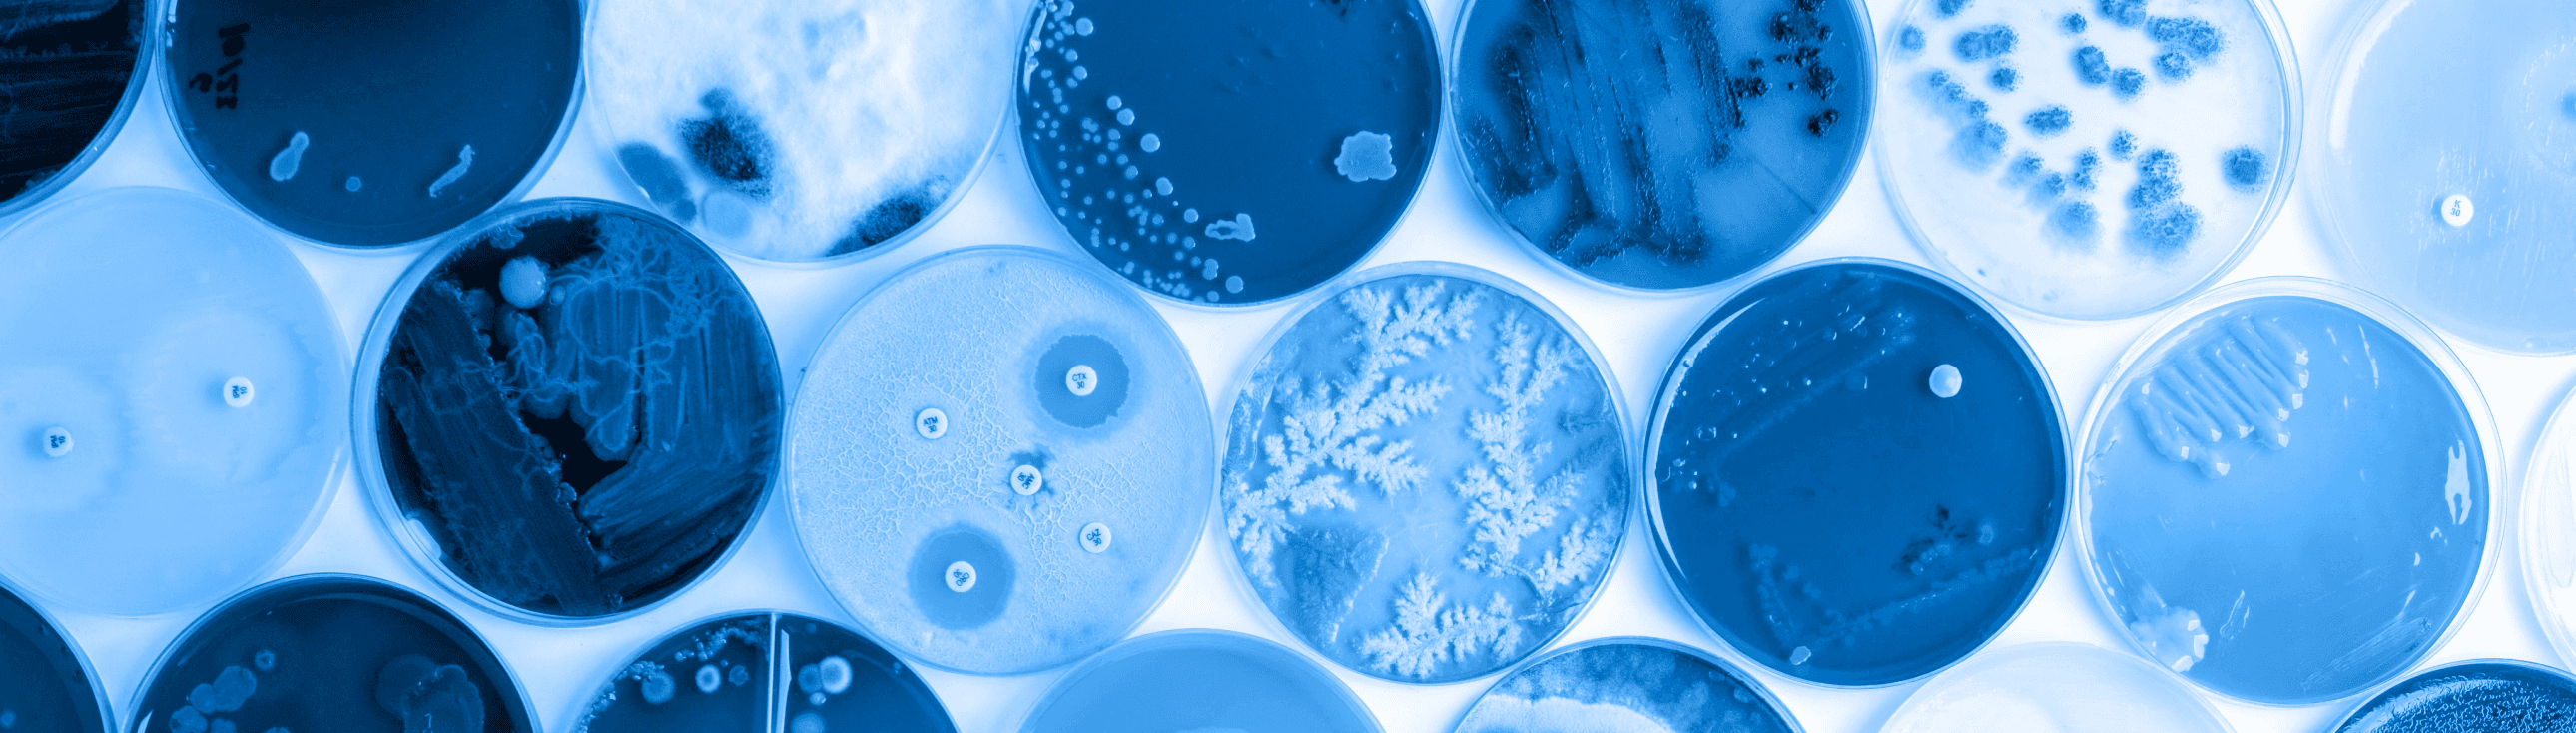

Commitment to
Quality and Trust.

Manufacturing practices are reviewed to ensure:
- Batch records and full production traceability
- Raw material and finished product testing
- Controlled storage and handling at every stage
Specific certifications or regulatory approvals are disclosed only where applicable and verifiable.
Testing Standards
Quality testing is an essential part of ensuring product safety and consistency. Where available, Nutrai products undergo testing to verify key quality parameters before reaching the market.
Testing is conducted internally or through independent third-party laboratories, depending on the product and market requirements. Detailed testing documentation is shared when available.




QR Code Verification
By scanning the QR code, customers can:
✓ Confirm product authenticity
✓ Get exclusive discount
QR verification availability may vary depending on product and market.
Transparency
Wellness, delivered.
Get the latest from Nutrai, product updates, science-backed insights, and simple ways to support your everyday health.
Information on this site is for general informational purposes only and is not a substitute for advice from a physician or other qualified health professional.
Nutrai © 2026